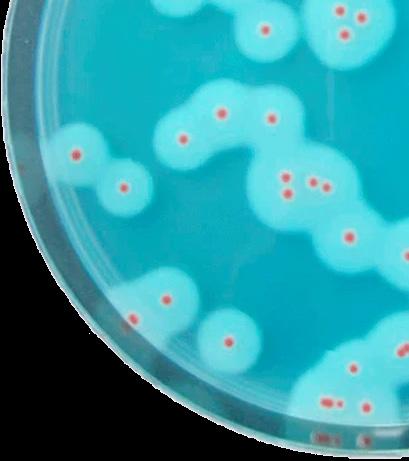

SCANDIAGNOSTIC






JANUAR NYHETSBREV



Sid 2-3
Sid 4-5
Sid 6-7


RAPID' B. Cereus

Termometrar och loggers



Det är 4 mykotoxiner i en extraktion




![]()












Sid 2-3
Sid 4-5
Sid 6-7


RAPID' B. Cereus

Termometrar och loggers



Det är 4 mykotoxiner i en extraktion





Bacillus cereus är en bakterie som förekommer naturligt i miljön, särskilt i jord, damm och vegetabiliska produkter. Den utgör en livsmedelsrisk eftersom den kan orsaka två typer av matförgiftning: en emetisk (kräkningstyp) och en diarrétyp, beroende på de toxiner som bakterien producerar.
Livsmedelsrisker med Bacillus cereus:
• Emetisk typ (illamående och kräkningar):
• Orsak: Produktion av ett stabilt toxin (cereulid) i livsmedlet, som inte förstörs vid uppvärmning.
• Inkubationstid: Kort, vanligtvis 0,5–6 timmar efter intag.
Symptom: Akut illamående, kräkningar och ibland magsmärtor. Symptomen varar vanligtvis i 6–24 timmar.
• Associerade livsmedel: Rätter med ris (särskilt stekt ris), pasta, gröt och andra stärkelserika livsmedel som har förvarats vid felaktiga temperaturer efter tillagning.
Orsak: Produktion av ett värmekänsligt enterotoxin i tarmen när bakterien intas.
• Inkubationstid: 6–15 timmar efter intag.
Symptom: Vattnig diarré, magsmärtor och kramper. Symptomen varar vanligtvis i 12–24 timmar.
• Associerade livsmedel: Kött, fisk, grönsaker, soppor, såser och mejeriprodukter, särskilt om de har förvarats eller tillagats på ett otillräckligt sätt.
En av de mest använda validerade metoderna för identifiering och räkning av Bacillus cereus är ISO 7932. I denna metod är inkubationstiden minst 40 timmar och det krävs att du morfologiskt kan identifiera Bacillus cereus på blodagar. Rapid B. cereus kan inkuberas i upp till 21 timmar och är lätt att läsa.
RAPIDs B. cereus är det första kromogena mediet som möjliggör kvantitativ analys av alla patogena Bacillus cereus. Bacillus cereus-gruppen, som kallas B. cereus sensu stricto, består av bl.a. av B. thuringiensis, B. mycoides, B. pseudomycoides, B. weihenstephanoensis B. cytotoxicus och naturligtvis B. cereus.

Riskfaktorer:
Felaktig förvaringstemperatur: Bacillus cereus kan snabbt föröka sig vid temperaturer mellan 10–50 °C. Förvaring av livsmedel i rumstemperatur under längre tid ger bakterien möjlighet att växa och producera toxiner.
Otillräcklig återuppvärmning: Återuppvärmning vid temperaturer under 60 °C kan vara otillräcklig för att döda bakterien eller inaktivera toxinerna.
Korskontaminering: Överföring från jord, damm eller kontaminerad utrustning till livsmedel.
Förebyggande åtgärder:
Snabb nedkylning: Se till att rester av varma rätter snabbt kyls ner till under 5 °C..
Korrekt återuppvärmning: Värm upp livsmedel till minst 75 °C för att minska risken för levande bakterier.
God hygien: Undvik korskontaminering genom att hålla utrustning, ytor och händer rena.
Tidskontroll: Låt inte livsmedel stå i rumstemperatur i mer än två timmar.

Genom att följa dessa riktlinjer kan risken för matförgiftning med Bacillus cereus minskas avsevärt.
Fördelar:
Snabbt – plattorna inkuberas i 24 +/- 3 timmar
Lättläst - röda kolonier med hög kontrast till den vita gloria
Den känsliga B. cytotoxicus kan också avläsas på plattan
Bakgrundsfloran (särskilt ett problem i råprover) hämmas
Ingen bekräftelse
AFNOR validerad
Komplett och flexibel lösning:
• Prefabricerade plattor
• Uttorkad + tillskott
• Plåtspridning
• Djupsådd

Camilla Larsson camilla.larsson@scandiagnostics.se
Tlf: 031-792 20 24
derimod om en række svabere, der kan gøre jeres rengøringskontrol meget nemmere.

EL- WIFI-TP / WiFi temperatursond datalogger
Denna logger är den idealiska lösningen för temperaturkontroll av kylar och frysar. Loggern är fixerad på utsidan, och sonden leds in i skåpet. Dataloggern fungerar trådlöst via WiFi och mätningarna kan, som
EL-WIFI-TH, ses på en PC med hjälp av mjukvara eller på EasyLog Cloud eller App.
→ Mätområde: -40°C till +125°C (±0,5°C)
→ Arbetsområde: -20°C till +60°C (±0,5°C)
→ Loggern använder ett inbyggt batteri som kan laddas via USB eller +5V adapter
→ Den medföljande programvaran är enkel att installera och använda
→ EL-WIFI-TP-loggern är IP 42 och sonden är IP67
→ Konfigurerbara hög- och låglarm med indikator

EL-WIFI-TH / WiFi temperatur- och fuktighetsdatalogger
EL-WiFi-TH mäter temperaturen och luftfuktigheten i miljön den befinner sig i. Data strömmas trådlöst över alla kompatibla WiFi-nätverk och kan ses på en PC med programvara eller på EasyLog Cloud eller App.
→ Mätområde: -20 till +60°C (-4 till +140°F) temperatur och 0 till 100 % fuktighetsmätområde
→ Streama och visa data trådlöst på EasyLog Cloud, appen eller på en PC
→ Enkel sensorinställning med hjälp av gratis program för PC
→ Visa och analysera flera sensorer, inklusive grafer av historiska data
→ Konfigurerbara hög- och låglarm med indikator
→ Sensorminnet sparar all data, även om WiFi är tillfälligt frånkopplat
EasyLog Cloud
EasyLog är en molnbaserad lösning för att konfigurera och analysera data som samlats in från EasyLog WiFi-dataloggrar. Den låter dig ställa in mätparametrar, visualisera data i grafer och generera detaljerade rapporter, vilket gör det enkelt att effektivt övervaka kritiska mätningar som temperatur och luftfuktighet.
Systemet kan enkelt skalas för att möta dina behov. Perfekt för allt från kompakta system med bara några få mätpunkter till företagslösningar med tusentals enheter över hela världen.
EL-USB-2-LCD+ Temperatur- och luftfuktighetsdatalogger USB-logger som mäter både temperatur och relativ luftfuktighet. Med en knapptryckning kan du använda den inbyggda displayen för att växla mellan aktuella, lägsta och högsta temperaturloggar som ses under sessionen för både temperatur och luftfuktighet. Loggern använder samma mjukvara som EL-USB-1-PRO och ställs in och läses ut via USB-porten.
→ -35 till +80°C / 0 till 100 % RH
→ Hög noggrannhet (0,5°C / 0,5%RH)
→ Kan lagra över 16 000 avläsningar
→ Konfigurera och ladda ner data via USB
→ Programmerbara larmgränser
EL-USB-1-PRO Temperaturlogger egnet til industri
Denna datalogger är tillverkad av rostfritt stål, vilket ger skydd mot korrosion, stötar och vatteninträngning. Loggern är IP67/NEMA 4X godkänd. Ställ enkelt in loggern och visa nedladdade data genom att ansluta enheten till en PCs USB-port och använda den kostnadsfria EasyLog-mjukvaran som medföljer. Data kan sedan plottas, skrivas ut och exporteras till andra applikationer för detaljerad analys. Levereras med ett specialiserat högtemperatur ⅔ AA-batteri.
→ -40 till +125°C
→ Tillverkad i rostfritt stål (SS 316).
→ Kan lagra över 32 000 avläsningar
→ Konfigurera och ladda ner data via USB
→ Programmerbara larmgränser

EasyLog USB-mjukvara är ett verktyg för att konfigurera och analysera data som samlas in från EasyLog USB-dataloggrar. En användarvänlig Windows-baserad guide förenklar inställningen av din logger, så att du kan välja ett loggernamn, mätparametrar och loggningshastigheter. Data kan laddas ner i grafiskt format med hjälp av programvaran EasyLog, där du kan föra muspekaren över grafen för att se tidsstämplade loggar, exportera all data till Excel för vidare analys eller se genomsnittlig statistik över tid genom EasyLog Summary Report.





1 2
är 4 mykotoxiner i en extraktion
Kvantitativmed ofarligt extraktionsmedel - möjlighet till portabel lösning
RIDA®QUICK DON RQS ECO
DON (Deoxynivalenol) är ett trichothecen mykotoxin. Den produceras av svampar i släktet Fusarium. DON finns framför allt i växtprodukter och spannmål. DON är det mest utbredda toxinet av de mer än 100 kända trichothecenerna i Europa och Nordamerika.
RIDA®QUICK
RIDA®QUICK kvantitativa mykotoxintester är laterala flödestester som kombinerar enkla testprotokoll med minimala utrustningskrav. Mykotoxintestning med RIDA®QUICK-produkter är lätt och robust på samma gång. En kort utbildning i testerna är tillräcklig för att generera tillförlitliga kvantitativa resultat.
RIDA®QUICK Fumonisin RQS ECO
Fumonisiner är cancerframkallande och mycket giftiga metaboliter som produceras av Fusarium verticillioides, som växer värdspecifikt på majs. De toxiska koncentrationerna av Fumonisin varierar avsevärt beroende på djurart.
3 4 5
• Flera mykotoxinbestämningar är möjliga med endast en provberedning med den nya universella extraktionsbufferten
• Bärbart system (t.ex. i fält eller mottagningspunkter för råvaror) som använder programvaran RIDA®SMART APP i kombination med en godkänd Android-smartphone eller med RIDA®SMART BOX (med powerbank)
• Snabbt: kvantitativa resultat efter 3 – 5 minuters inkubationstid
• Vattenbaserad extraktion: inga organiska lösningsmedel (koncentrerat vattenhaltigt extraktionsmedel ingår)
• Kostnadseffektiv: minimal laboratorieutrustning. Inga extra kostnader för inköp av organiska lösningsmedel eller avfallshantering.
RIDA®QUICK Ochratoxin ECO
Mykotoxinet Ochratoxin A produceras av svampar av släktena Aspergillus och Penicillium. Förutom sin uttalade nefrotoxicitet uppvisar Ochratoxin A hepatotoxiska, teratogena, cancerogena och immunsuppressiva egenskaper. Konsumtion av förorenade livsmedel och foder av vegetabiliskt ursprung, men också av animaliskt ursprung, utgör en särskild hälsorisk för människor. Ochratoxin A har redan påvisats i grisblod och njurar och i humant blod och bröstmjölk.
RIDA®QUICK T-2 / HT-2 RQS ECO
T-2- och HT-2-toxiner tillhör trichothecengruppen av mykotoxiner och produceras av svampar av släktet Fusarium.
T-2- och HT-2-toxiner finns ofta i jordbruksprodukter, även om förekomsten och koncentrationerna som hittats visar stor regional variation. På grund av deras höga cytotoxiska och immunsuppressiva verkningssätt är T-2/HT-2-toxiner ett hot mot människors och djurs hälsa.

Detektionsgräns (LoD): Det finns validerade protokoll för en rad olika matriser. Fråga oss om just dina prover.
RIDA®QUICK DON RQS ECO (Art. Nr. R5911) – 0,2 mg/kg för majs och 0,1 mg/kg för veteprover
RIDA®QUICK Fumonisin RQS ECO (Art. Nr. R5606) – 0,5 mg/kg för majsprover
RIDA®QUICK Ochratoxin ECO (Art. Nr. R5404) – 2 µg/kg för majs- och veteprover
RIDA®QUICK T-2 / HT-2 RQS ECO (Art. Nr. R5304) – 50 µg/kg för majs, 63 µg/kg för vete och 64 µg/kg för havreprover Kvantifikationsgräns (LoQ):
RIDA®QUICK DON RQS ECO (Art. Nr. R5911) – 0,5 mg/kg för majs och 0,4 mg/kg för veteprover
RIDA®QUICK Fumonisin RQS ECO (Art. Nr. R5606) – 0,6 mg/kg för majsprover
RIDA®QUICK Ochratoxin ECO (Art. Nr. R5404) – 5 µg/kg för majs och 4 µg/ kg för veteprover
RIDA®QUICK T-2 / HT-2 RQS ECO (Art. Nr. R5304) – 50 µg/kg för majs, 200 µg/kg för vete och 100 µg/kg för havreprover

Nu är det möjligt, genom att använda RIDA®QUICK Mycotoxin ECO Extractor, att göra en extraktion och använda den för de 4 olika laterala flödessatserna.
För läsning används RIDA®SMART APP, antingen separat med en mobiltelefon, eller i kombination med en RIDA®SMART BOX.
RIDA®SMART BOX är en innovativ avbildningsanordning för sidoflöde för automatisk avläsning av RIDA®QUICK mykotoxin LFD-tester i kombination med RIDA®SMART APP, för analys och kvantifiering
Denna kombination är den perfekta systemlösningen för ditt laboratorium. På grund av sin robusta design är boxen väl skyddad mot damm och ger alltid den optimala mätmiljön för LFD-testerna. Den enkla och intuitiva hanteringen via RIDA®SMART APP är möjlig på alla Android-baserade system.

Isaac Newton. Även om historien om äpplet som träffade Issac Newton i huvudet måste anses vara en bra men felaktig historia, är det ändå alltid den som läggs som grund för utvecklingen av "The Universal Law of Gravitation" och Newtons rörelselagar .
Biokemi
Danmark
Cristiana@foodiagnostics.dk Telefon: 2594 8086
Færøerne
Båda delarna beskrevs i Principia 1687. Isaac Newton formulerade de tre berömda rörelselagarna som ligger till grund för klassisk mekanik. De beskriver hur krafter påverkar föremåls rörelse.

onell mot produkten av deras massor och omvänt proportionell mot kvadraten på avståndet mellan dem." Större massa, större attraktion: Ju större massorna av de två objekten, desto större attraktionskraft mellan dem. Därför upplever vi en mycket stark gravitationskraft på jorden, eftersom jordens massa är stor.
Runi@foodiagnostics.dk Telefon: (298) 591667
1. Newtons första lag (tröghetslag): "En kropp förblir i vila eller i jämn, rätlinjig rörelse om den inte påverkas av en yttre kraft."
2. Newtons andra lag (Law of Force): "Den resulterande kraften på en kropp är lika med dess massa multiplicerad med dess acceleration." F = m*a
3. Newtons tredje lag (Lagen om handling och motreaktion): "För varje kraft finns en lika och motsatt riktad reaktionskraft."
Newtons gravitationslag: "Alla partiklar med massa attraherar varandra med en kraft som är proporti-
Danmark

Hygiejne & ECA
Danmark
Tonny@foodiagnostics.dk Telefon: 4056 5659
Ehsan@foodiagnostics.dk Telefon: 2222 7592
Vikten av avstånd: Kraften minskar snabbt när avståndet mellan föremålen ökar. Detta beror på att kraften är omvänt proportionell mot kvadraten på avståndet (r2r^2r2), vilket innebär att om avståndet mellan två objekt fördubblas, reduceras kraften till en fjärdedel.
Förutom att utforma dessa (och många andra) lagar, var det Newton som visade att vitt ljus kan delas upp i olika ljusfärger. Newton utvecklade, nästan samtidigt med den tyske matematikern Gottfried Wilhelm Leibniz, en ny form av matematik som vi idag kallar kalkyl (differential- och integralkalkyl).
Kalibrering/verifiering av instrument
Det är nu möjligt att förregistrera ditt instrument online för verifiering, kalibrering eller service.
Se mer här: checka adressen på vår hemsida


KURSER 2024
Vi håller löpande kurser. Kontakta oss för mer information

Scandinavian Diagnostics AB Norra Ågaten 10 41664 Göteborg
Sverige
Tlf: 031-792 2020
Mail: order@scandiagnostics.se
www.scandiagnostics.se och anmäl dig till vårt digitala nyhetsbrev eller 'följ' oss på Facebook och LinkedIn




